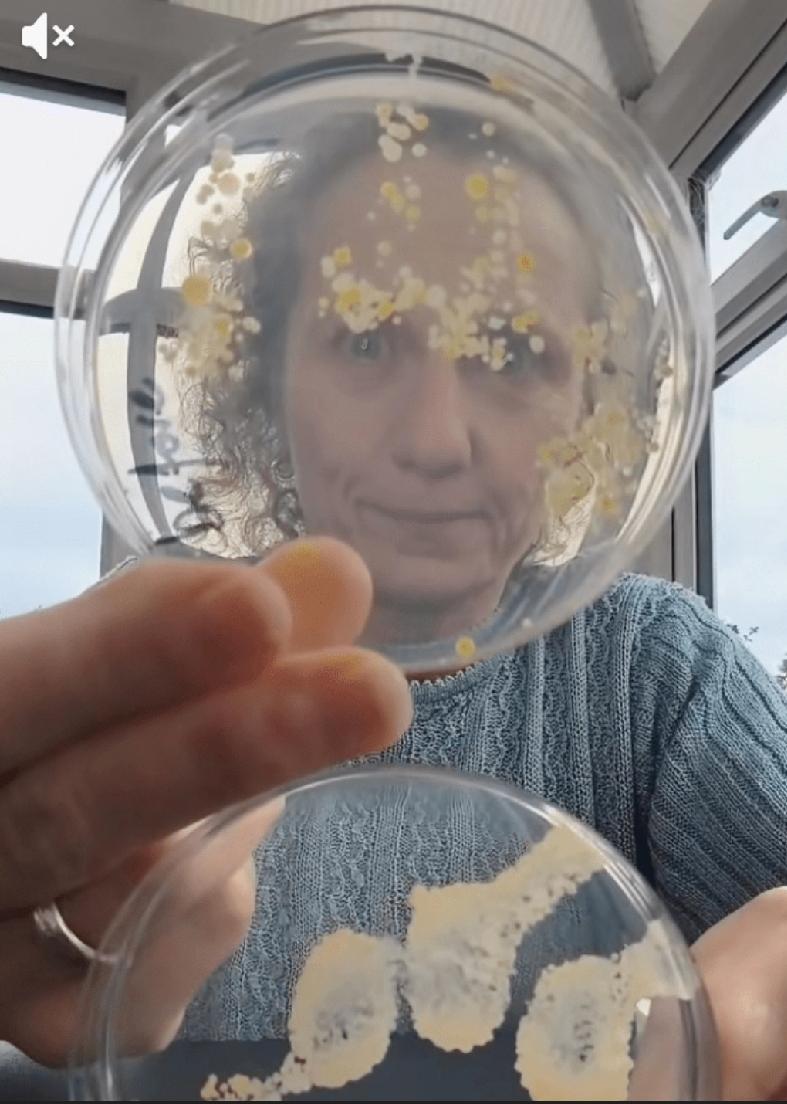
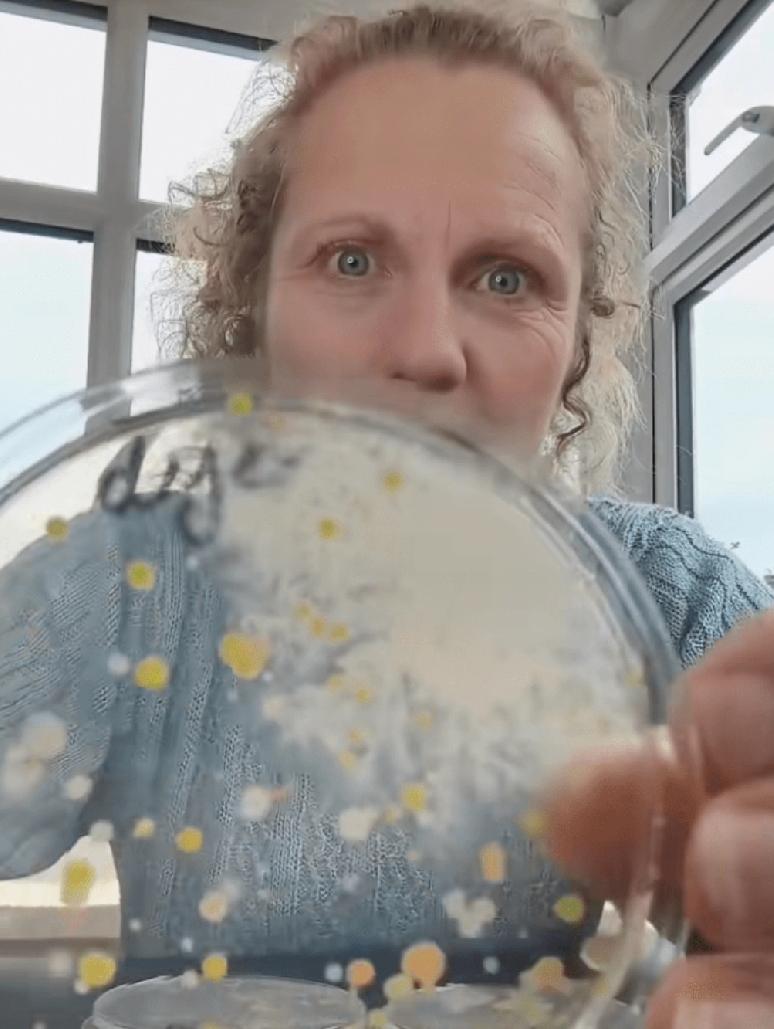

英国教育机构「Devon Science」创办人、科学家麦克拉伦(Ruth MacLaren)近日在社交平台分享一项震撼实验,揭示公共厕所烘手机吹出的风中布满细菌与真菌。经一夜培养,培养皿上长出多种细菌菌落,而一般空气样本几乎「零生长」。对此,麦克拉伦直言:「这就是我不用烘手机的原因。」影片上传后疯传,累积观看次数突破一千万,引发全球网民热议。



英国教育机构「Devon Science」创办人、科学家麦克拉伦(Ruth MacLaren)近日在社交平台分享一项震撼实验,揭示公共厕所烘手机吹出的风中布满细菌与真菌。经一夜培养,培养皿上长出多种细菌菌落,而一般空气样本几乎「零生长」。对此,麦克拉伦直言:「这就是我不用烘手机的原因。」影片上传后疯传,累积观看次数突破一千万,引发全球网民热议。

作者最新文章
热门分类
国际TOP
国际最新文章